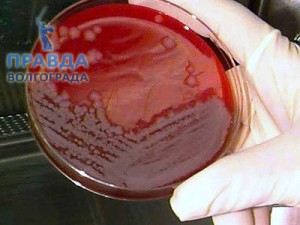

Мясные продукты, инфицированные сибирской язвой, по государственному контракту оказались на кухне в детском оздоровительном лагере и кардиологическом центре.
Мясные продукты, инфицированные сибирской язвой, по государственному контракту оказались на кухне в детском оздоровительном лагере и кардиологическом центре.
Напомним, что уже в первой декаде августа текущего года, владелец фермы в одной из волгоградских деревень, забил больную корову, а спустя некоторое время попал в больницу с сибирской язвой.
Тушу коровы, которая весила более 150-ти килограмм, после забоя, перепродали нескольким людям, которые совершенно не обратили внимания на отсутствующую сопроводительную документацию, являющуюся по обыкновению обязательной. Последним из перекупщиков стал замдиректора двух компаний «Радуга» и «Леда», господин Чубинидзе.
Произведя раздел туши на три части, он отправил зараженное мясо в детские учреждения, где затем и было зарегистрировано несколько случаев заражения с госпитализацией. По данному факту, ГУ МВД города Волгоград уже возбуждено уголовное дело в отношении Чубинидзе и еще нескольких человек, которых власти посчитали распространителями сибирской язвы.















